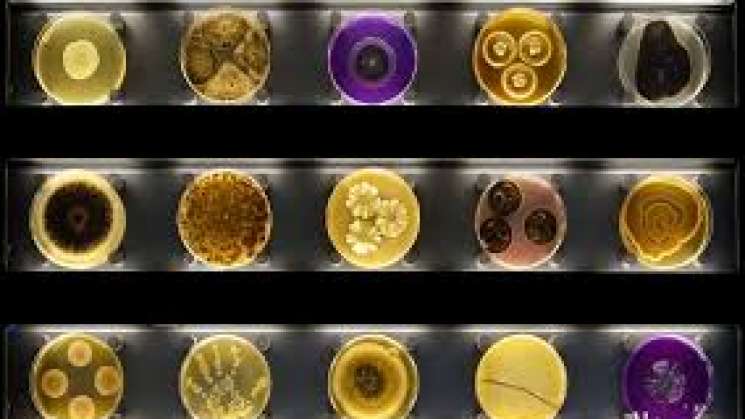
IPN tiene la colección más importante de microorganismos

Agencias
Oaxaca.-La Colección Nacional de Cepas Microbianas y Cultivos Celulares del Centro de Investigación y de Estudios Avanzados (Cinvestav) del IPN es la más importante del país.
Actualmente cuenta con un acervo de 3 mil microorganismos de importancia industrial tanto en el ámbito de la salud como en el de la agricultura y la alimentación.
Se fundó bajo el nombre de “Colección de Cultivos Microbianos” como un organismo dependiente del Departamento de Biotecnología y Bioingeniería del Cinvestav.
Tiene como objetivo obtener, preservar, clasificar, estudiar y documentar de manera completa y accesible, un acervo de cultivos de microorganismos auténticamente puros, estables y bien clasificados de interés específico.
Fue reconocida por el Centro Mundial de Datos de Microorganismos (WDCM), el cual es un vehículo para las redes de centros de recursos microbianos y se desempeña como un medio de información para los clientes de estos centros. Se identificó con el acrónimo CDBB (Colección del Departamento de Biotecnología y Bioingeniería) con el registro 500.
Se afilió a la Federación Mundial de Colecciones Microbianas (WFCC), bajo la dirección de la Profesora Jovita Martínez Cruz.
En 1982 se realizó el primer católogo de la Colección en donde contenía información sobre el número de cultivos que disponian, funcionalidad y condiciones de crecimiento.
En 1992 en conjunto con el Departamento de Computación y la Conabio, iniciaron el proyecto para generar su primer sistema de base de datos.
En 2000 Se descentralizó del Departamento de Biotecnología y Bioingeniería, reconociéndose como Colección Nacional de Cepas Microbianas y Cultivos Celulares, la cual tiene como misión ofrecer apoyo a los profesionales en su labor cotidiana, les brindan asesoramiento en el manejo y control de los microorganismos y en el depósito de cepas para salvaguardar sus propiedades.
En ese mismo año se incorporó a la Federación Latinoamericana de Colecciones de Cultivos, quien funge como una Subcomisión de Colecciones Microbianas.
2010
Comienza la construcción del edificio (actualmente donde reside la Colección). Este lugar fue pensado y diseñado exclusivamente para albergarla. Dos años después inician las actividades formalmente en dicho sitio.
2016
Se desarrolló un proyecto para la optimización de la página web de la Colección, donde se encuentra también la base de datos, la cual continúa operando actualmente.
2019
Su importancia radica en tres puntos: la docencia, la investigación y la aplicación del sector privado.
En cuanto a sus servicios se encuentran: conservación de microorganismos, depósito y resguardo de cepas, autentificación e identificación de cepas, documentación actualizada de los cultivos a través de catálogos y base de datos en línea; asesoramiento a clientes.
Te podría interesar...


Esta conversación es moderada acorde a las reglas de la comunidad “Ciudadanía Express” . Por favor lee las reglas antes de unirte a ella.
Para revisar las reglas da clic aquí